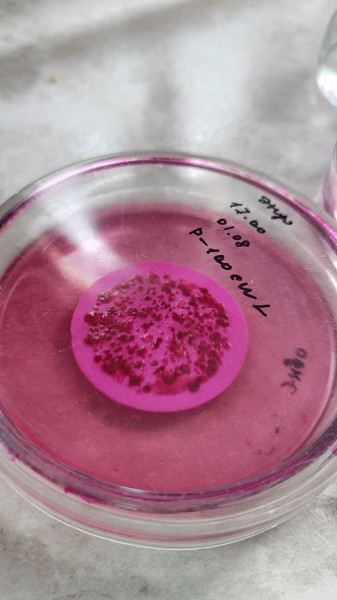
0023

Expedition onboard the R/V “Akademik Koptyug” on August 1-10, 2024
On August 1-10, 2024, within the State Assignments “From the cell to the ecosystem: Investigation of the ultrastructure of hydrobionts and their communities in the evolutionary and ecological aspect by methods of cell biology and genomics” (0279-2021-0008) (led by Likhoshway Ye.V.) and “Investigation of selected genes and proteins of Baikal diatoms by means of bioinformatics and physicochemical biology methods” (0279-2021-0009) (led by Petrova D.P.), a research expedition onboard the R/V “Akademik Koptyug” was carried out to determine by a complex of methods the extent of anthropogenic impact on the coastal and pelagic zones of Lake Baikal in the areas of influence of three rivers into which sewage is discharged: Pokhabikha (Slyudyanka), Maksimikha (Maksimikha settlement), and Tyya (Severobaikalsk). The staff of the Department of Cell Ultrastructure participated in the expedition: prof. Likhoshvay Ye.V. (Dr. Sc. (Biology), head of the team Zakharova Yu.R. (Cand. Sc. (Biology), senior staff scientist Firsova A.D. (Cand. Sc. (Biology), research scientist Bashenkhaeva M.V. (Cand. Sc. (Biology), research scientist Rodionova Ye.V. (Cand. Sc. (Biology), main specialist Bairamova E.M., main specialist Efimenko B.E., Khilkhanova D.V., tech. Parfenov D.I.); Laboratory of Biogeochemistry (senior staff scientist Chebykin E.P. (Cand. Sc. Chemistry), senior staff scientist Kulikova N.N. (Cand. Sc. (Biology); Laboratory of Ichthyology (senior staff scientist Khanaev I.V., leading engineer Usov S.V.) and Laboratory of Hydrochemistry and Atmospheric Chemistry (Cand. Sc. (Geology), research scientist Chebunina N.S.).
Samples were taken before and after wastewater discharge, in the effluent pipe and at radial transects at different distances from the mouth into Lake Baikal. Remote coastal (3 to 6 km from the estuary) and pelagic (3 km from shore) stations served as control stations.
A total of 56 samples were taken for hydrochemical research (including 15 samples in the zone of influence of the Pokhabikha River, 16 samples in the zone of influence of the Maksimikha River, and 25 samples in the zone of influence of the Tyya River). Dissolved oxygen, pH, electrical conductivity, and biogenic elements (nitrite, ammonium, phosphate, and silicon) were determined during the fieldwork on the vessel. The results of the chemical analysis of the “treated” waste water of the town of Slyudyanka showed that the standards of maximum permissible impact on the unique ecological system of Lake Baikal are exceeded 44 times in terms of phosphate content (phosphorus) and 117 times in terms of ammonium ions. In the “treated” waste water of the town of Severobaikalsk the content of ammonium ions exceeded the normative values by 16 times, phosphates (for phosphorus) by 83 times. Water samples for ionic composition, total and dissolved phosphorus were frozen and transported to the Laboratory of Hydrochemistry and Atmospheric Chemistry for further analysis.
To determine the geochemical composition of water (72 chemical elements) and total mineralization by the ICP-MS method, a total of 246 samples were collected, filtered (0.45 µm) and fixed for further analysis in the biogeochemistry laboratory. The pH values were also measured in all samples. Water samples were taken at three main sites: in the zones of influence of the Pokhabikha, Maksimikha, and Tyya rivers on the adjacent Baikal littoral (coastal, interstitial waters, as well as in the water area - surface, bottom, and intermediate waters at pre-planned stations). River water was also sampled upstream of effluent discharges (Pokhabikha River, Tyya River) or the settlement (Maksimikha River) and at the mouths of the rivers. Wastewater from sewage treatment plants (STPs) in Slyudyanka and Severobaikalsk towns was sampled directly from discharge pipes into rivers (Pokhabikha River, Tyya River). Water samples were also collected at background/conditionally background stations in each area: 3 or more kilometers frontally and laterally (50 m from the cut-off) from river mouths. In addition to sampling of coastal and interstitial waters, filamentous algae were collected in the estuary for biogeochemical studies. Besides, coastal and interstitial waters were also sampled in background (Cape Omagachan, Cape Khibelen, Cape Kedrovy, Solontsovaya Bay), conditionally background (Cape Kotelnikovsky, Cape Elokhin, Sagan Zaba Rock) and anthropogenically loaded (Khuzhir settlement - Shamanka Rock, port, Ogoi Island, Peschanaya Bay, Babushka Bay, Vnuchka Bay 2) areas of the Baikal coastal zone along the ship`s course.
Forty-five samples of benthic macroalgae were collected to determine the chemical elemental composition by ICP-MS and to use it them as indicators of anthropogenic pollution of the shallow water zone of Lake Baikal: 30 - Ulothrix zonata, 14 of them were collected in the coastal zone of conditionally background sites: Omagachan, Khibelen, Elokhin, Kedrovy, Kotelnikovsky, Sagan-Zaba Capes, Solontsovaya Bay, north of Sukhoi Ruchey settlement; 6 - Spirogyra sp., 3 - Stigeoclonium sp., 3 - Ireksokonia formosa and one sample - Elodea canadensis (under the discharge pipe from the sewage treatment plant of Severobaikalsk). Algae samples were washed in coastal water, then in the filtered Baikal water, cleaned of foreign impurities under a binocular, rinsed with distilled water, dried to air-dry condition, and hermetically packed. Statistical processing of macro- and microelement content data obtained in Ulothrix zonata of background and anthropogenically polluted areas of the shallow water zone will determine the expected possibility of its use as a bioindicator in the future.
To determine the total number of bacteria, culturable heterotrophs, and the composition of sanitary-pathogenic bacteria, 29 samples of sewage, river, and surface waters of Lake Baikal were investigated. During the sanitary-microbiological assessment of water sample quality, the number of generalized coliform bacteria, E. coli bacteria, enterococci, and total microbial counts were determined. At all monitoring stations in the pelagic zone of Lake Baikal, far from the local pollution sites studied, water quality indicators did not exceed the safety standards according to SanPiN 1.2.3685-21. It was found that wastewater discharged by treatment facilities of Slyudyanka and Severobakalsk, water at the mouth of the Pokhabikha and Tyya rivers, and surface water of the Baikal in the estuary water area do not meet the requirements of SanPiN 1.2.3685-21 for the maximum permissible amount of all studied indicators. In Barguzinsky Bay, in the recreational zone of the Maksimikha settlement, water samples taken from the Maksimikha River, the estuary, the Baikal coastal water and 50 m from the shore exceeded the maximum allowable number of enterococci.
For metagenomic analysis of microeukaryote and bacterial communities ( further DNA extraction and amplicon sequencing of 18S rRNA and 16S rRNA gene fragments), 17 water samples from the surface layer were filtered: 5 samples in the Pokhabikha River area, 5 samples in the Maksimikha River area, and 7 samples in the Tyya River area, and 3 integral samples 0-25 m 3 km from the mouth of the Pokhabikha River; 11 km 670 m from the mouth of the Maksimikha River, and 3 km from the mouth of the Tyya River. Samples were frozen in TE buffer and transported to the Cell Ultrastructure Department for further analysis.
To assess the effect of wastewater on diatom cells, samples were selected for silica deposition activity (PDMPO staining) and changes in expression of genes related to stress response using real-time PCR. In the area of the Pokhabikha River and the Maksimikha River, samples were taken at 4 sites; in the pelagic zone, samples were taken not only in the photic layer but also at depths of 50, 100 m and near the bottom. Samples were collected at 5 sites in the Tyya River area. For PDMPO staining, samples were fixed, for mRNA extraction samples were collected on filters, preserved and delivered to the Cell Ultrastructure Department for further analysis.
To analyze the influence of anthropogenic impacts on benthic diatom communities, 57 benthic samples were collected by divers from different substrates (rock, sand, silty sand, wood fragments) in the impact zones and at the monitoring stations. Preliminary investigation of microphytobenthos samples using light microscopy (LM) showed that the species composition of benthic diatoms is more diverse in the Pokhabikha River area. Many species of genera Navicula, Placoneis, and Amphora were found here. A single species of Gomphonema sp. dominates on rocks in other areas (near the Maksimikha and Tyya rivers). The diatom Didymosphenia geminata (Lyngb.) M. Schmidt vegetates well near the Tyya River. Quantitative and qualitative analyses of samples will be carried out, and diatom cell morphology will be studied in detail using SM and scanning electron microscopy (SEM) in the Cell Ultrastructure Department.
To analyze phytoplankton, water samples were collected from the photic layer (surface layer and integrated samples at deep-water pelagic stations) using a Niskin bathometer. Water transparency was determined with a Secchi disk. After determining temperature, pH, redox potential (ROP) and electrical conductivity of the water, samples were collected on filters for further examination of the samples by SEM, quantitative analysis of phytoplankton composition by LM. Samples for the cultivation of microalgae species were collected with a Juday net. Surface water temperature was 20-22.2°C, water transparency by Secchi disk varied from 1 to 5.5 m. A LM survey onboard the vessel during the expedition found that phytoplankton was not abundant and differed significantly in the three zones studied. River stations and stations closer to the shore (up to 100 m from the cut-off) were very poor compared to phytoplankton at stations farther from the shore. Plankton of the pelagic zone (3 km from shore) was the richest in composition and quantity. It was represented by diatoms (Bacillariophyta), golden algae (Chrysophyta), green algae (Chlorophyta), charophytes (Charophyta), blue-green algae (Cyanophyta) and dinophytes (Dinophyta). Phytoplankton in the Pokhabikha River influence zone was dominated by: convergent species Fragilaria radians (Kützing) D.M.Williams & Roun and Ulnaria acus (Kützing) Aboal, Lindavia minuta (Skvortzov) T.Nakov et al., Ankistrodesmus arcuatus Korshikov, Asterionella formosa Hassall, and Dinobryon divergens O.E.Imhof. Accompanying algae were the small green algae Mucidosphaerium pulchellum (H.C.Wood) C.Bock, Proschold & Krienitz, the charophytes Elakatothrix genevensis (Reverdin) Hindák, the colonial cyanobacteria Cyanodictyon planctonicum B.A.Mayer also occurred. In the Maksimikha River influence zone, in the phytoplankton, the most abundant cyanobacteria Dolichospermum flos-aquae (Bornet & Flahault) P.Wacklin, L.Hoffmann & Komárek, D. scheremetieviae (Elenkin) Wacklin, L.Hoffmann & Komárek and Gloeotrichia echinulata P.G.Richter, and the golden algae Dinobryon stipitatum Stein, the diatoms were mostly represented by the species Asterionella formosa. The diatoms Aulacoseira granulata (Ehrenberg) Simonsen, Lindavia minuta, Nitzschiа graciliformis Langre-Bertalot, Sinonsen et al. and Fragilaria radians/Ulnaria acus were dominant in the influence zone of the Tyya River. Dinobryon stipitatum and Dinobryon divergens O.E.Imhof were dominant among the golden algae and Coenococcus planctonicus Korshikov were more abundant among the green algae. Samples will be further analyzed by LM and SEM, DNA will be isolated, and high-throughput sequencing and bioinformatic analysis of the sequences obtained to determine the taxonomic diversity of microeukaryotes.
The expedition participants thank the team of the R/V “Akademik Koptyug” for the assistance in sampling and the precise and well-coordinated work.
Microphoto caption. Microalgae. СМ. 1 – Gloeotrichia echinulata; 2 – Dolichospermum flos-aquae; 3 – Dolichospermum scheremetieviae; 4 – Cyanodictyon planctonicum; 5 – Dinobryon divergens; 6 – Dinobryon stipitatum; 7 – Uroglena volvox Ehrenberg; 8 – Ceratium hirundinella; 9 – Aulacoseira baicalensis; 10 – Aulacoseira granulata; 11 – Stephanodiscus meyeri; 12 – Lindavia minuta; 13 – Ulnaria acus /Fragilaria radians; 14 – Asterionella formosa; 15 – Spirulina sp.; 16 – Sphaerocystis planctonica; 17 – Coenococcus planctonicus; 18 – Ankistrodesmus arcuatus; 19 – Chlamidomonas sp.; 20 – Elakatothrix genevensis; 21 – Glenodinium sp.; 22 – Coelastrum pseudomicroporum Korshikov; 23, 24 – benthic diatoms. Scale: 1 – 100 µm; 2-24 – 10 µm.

-fb60f024c6.jpg)





















-16142dfdc9.jpg)
-3beaa5f8d5.jpg)
































-b653b2c528.jpg)





















